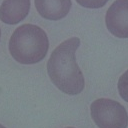
RBC

Blood Analysis
Analyse the Peripheral Blood Smear with cutting-edge AI technology and make the diagnosis easier and faster
Blood Findings
RBCs

Malaria

WBCs

Platelet
Urine Analysis
Elevate the Urine Microscopic Analysis with our state-of-the-art AI technology
Urine Findings

RBCs

Crystals

Casts

Yeast
Semen Analysis
Get comprehensive insights on the Semen Samples with robust AI technology
Semen Findings
Normal
Amorphous
Pyriform
Tapered
Key Benefits & Features
Accelerated Results
Get faster diagnostics with reduced turnaround time.
Limitless Storage
Enjoy endless digital pathology storage, keeping all your data secure and accessible.
On-Demand Access
Access reports anytime, anywhere, for seamless workflow integration.
Enhanced Diagnostics
Simplify the identification of rare cases with advanced tools at your fingertips.
Collaborative Expertise
Enable remote collaboration on special cases, bringing the best minds together.
Product Specifications
+Components:
- • Camera Unit
- • Computing Unit
- • Casing
Computing:
- Processor
- •Quad-core 64-bit Arm Cortex -A76 CPU, running at 2.4GHz
- Memory (RAM)
- •LPDDR4X-4267 8GB SDRAM
Camera:
- •Resolution: 12.3 megapixels
- •Sensor Size: 7.9 mm diagonal
- •Pixel Size: 1.55 um x 1.55 pm
- •0.5x Reduction Lens Adapter: Specific to Microscope Brand
External Interface :
- •4 x USB Type-A ports
- •1 x Gigabit Ethernet (RJ45) port
- •2 x Micro HDMI ports
- •1 x USB-C power input port (5V/5A)
Electrical Specification :
- • Camera Unit
- • Computing Unit
- • Casing
External Interface :
- •Input Voltage: 100-240V AC, 50-60Hz
- •Power Delivery Profiles: 5V/5A, 9V/3A, 12V/2.25A, 15V/1.8A (maximum 27W)